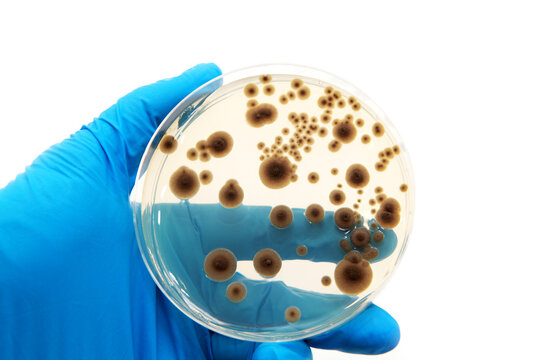

Composition and Properties
Polysaccharide is an all-inclusive term for a variety of starchy, hydrocolloid substances derived from plants or microbes. In the food industry, polysaccharides play a crucial role in creating textures, thickening liquids, and stabilizing oil-and-water solutions. In the cosmetic industry, polysaccharides work primarily as stabilizers that allow multiple types of oils to be blended together and combined with water-based ingredients. A tiny amount of polysaccharide powder mixed with water creates liters of slippery substance that is less slimy than PEO, PG, and other emulsifiers.
Many polysaccharides are usually mixed with other lubricant bases to create very personalized lubes. Although polysaccharides can be used as single-ingredient-lubes, this is uncommon in the fisting community. This disuse is due to lack of knowledge about the highly viscous and lubricious nature of these polysaccharides.
The two most common polysaccharides are gums and cellulose.
Dozens of unique gums can be transformed into fisting lubes. The three most common include:
- Xanthan | Derived from microbial fermentation of sugar in specialized factories.
- Guar | Extracted industrially or manually from the seeds of Guar or Cluster beans, a popular legume in India.
- Carob | Extracted industrially or manually from the pod seeds of locust trees.
Hydroxyethyl cellulose and carboxymethyl cellulose can be purchased as powders or premixed lubes. Many lube manufacturers use one of these two cellulose agents as the base in their lubes.
Lube enthusiast can create organic polysaccharide lubes with common food items such as corn starch, potatoes, legumes, and other starchy vegetables.
Polysaccharide lubes may be referred to as water-based or emulsifier lubricants. Water-based is an umbrella term that includes glycerine-based lubes, polysaccharides, and PEO-based lubes. Emulsifier is an umbrella term that includes PEO lubes, some obstetrical lubes, polysaccharide lubes, and pectin-sourced lubes.
VOCABULARY
Hydrocolloid
- NOUN A substance which forms a gel in the presence of water.

Figure 1.2: Locust Pods on Honey Locust Tree
Endoderm from seeds from locust pods create carob gum.


/u_lubrication_(unambiguated)_lubrication_data_sheets.png)